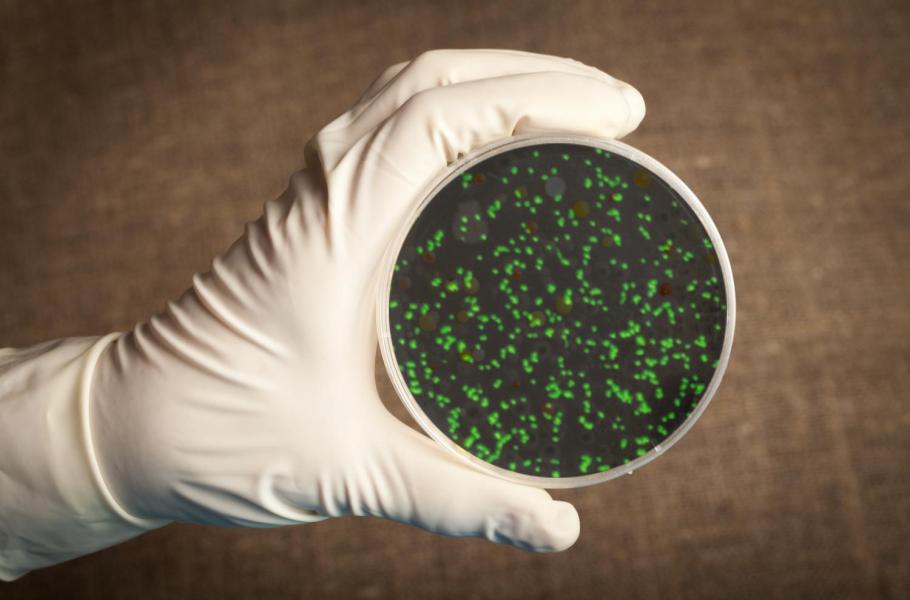

Japonští vědci v laboratoři vzkřísili mikroby staré 100 milionů let
Mikroorganismy ze sedimentů uložených na mořském dně v období křídy bez problémů přežijí ve stavu klidu až do dnešní doby
Mnohé mikroorganismy dovedou přečkat nepříznivé období a zůstat naživu. Může to trvat velmi dlouho. Třeba i déle než 100 milionů let. Právě to nedávno zjistil tým mikrobiologů, který vedl Yuki Morono z agentury Japan Agency for Marine-Earth Science and Technology v japonském Kóči.
Vědci prozkoumali vzorky mořských sedimentů, které pocházely z pustého mořského dna, z hloubek 3 700 až 5 700 metrů, v oblasti jižního Pacifiku. Šlo o sedimenty staré 13 až téměř 102 milionů let. V těchto místech bývá k dispozici extrémně málo živin a mikroorganismy tam podle všeho často živoří, takže se běžně uchylují do stavu dormance, tedy do fáze klidu. A v tomto stavu pak vydrží téměř věčně.
TIP: Nesmrtelní mikrobi ze Sibiře: Jak velkou hrozbu představují tisíce let zmražené viry?
Badatele nicméně překvapilo, když zjistili, že téměř všichni mikrobi ze vzorků, včetně těch nejstarších sedimentů byli živí, jen se nacházeli v klidové fázi. Když vědci mikrobům nabídli živiny, především v podobě sloučenin dusíku a uhlíku, mikroorganismy, které náležejí k různým skupinám bakterií, rychle vzkřísili. Koho by napadlo, že druhohorní mikrobi z přelomu spodní a svrchní křídy, bez problémů přežijí až dodneška. Jak je vidět, naše představy o schopnostech a možnostech mikrobů stále ještě pokulhávají za realitou.